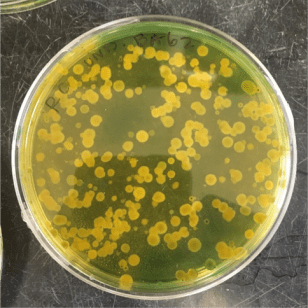
Vibrio5

This guest post is by Rachel Canty. Rachel is a Master’s student at UNC Institute of Marine Sciences. Her research focuses on coastal microbial ecology, specifically on competing different strains of the human pathogenic bacterium, Vibrio vulnificus, against one another. Rachel’s claim to fame is that she once swam on a relay with Katie Ledecky (5-time Olympic gold medalist) in high school and has been living in the shadow of that day ever since.
Learn more about Rachel and her work on her website or follow her on twitter @RachelCanty
As a marine scientist, and particularly a microbial marine scientist, I have come to learn a lot about the photosynthetic microorganisms, phytoplankton. They are the “lungs of the sea”; they contribute 50% of the oxygen we breathe. Cyanobacteria (a type of phytoplankton) have been named as the first photosynthetic organism, without which, multicellular life would not be possible.
Even though phytoplankton have literally given us the air we breathe, they get a bad rap. Why? The answer is phytoplankton blooms.

What appears to be a Shepard mix swimming through the slime of an algal bloom. (Ildar Sagdejev/Wikipedia)
Because of their bad reputation (not unlike the one Taylor Swift has), every marine science student can recite the major components of a phytoplankton bloom, even those who have never worked with phytoplankton a day in their life. 1) Excess nutrients enter a body of water.2) Phytoplankton go crazy (alright, I’m personifying a bit). The locals complain about aesthetics. 3) Phytoplankton went too crazy and died. Their tiny carcasses sink to the bottom (I’m embellishing, as well). 4) Respiration uses up the available oxygen, resulting in hypoxic bottom water conditions. 5) Fish die. The economy suffers. People finally start caring about where these excess nutrients came from.
I don’t mean to knock those who study phytoplankton blooms by suggesting I’ve got it all figured out. Tracking the sources of these nutrient is a commendable and formidable task. Understanding the interactions of phytoplankton with other microorganisms, macroorganisms, and the environment is daunting. But I will say, I’m a little over the phytoplankton bloom. Been there, learned that.
That’s why, when I found out that the genus of bacteria I work with, my little “laboratory babies”, have recently been implicated as blooming bacteria, I knew I had to write about them. I had to let the world (or at least the readers of the UNdertheC blog) know. It’s like writing about your child’s wrongdoings and being proud of it (not that I have children, but I imagine it’s like that). But maybe after I articulate this you’ll understand why I want to show them off
To give context, I work with the bacteria Vibrio vulnificus. I feel as though the sentiment attributed to this species can’t be described with a word, but more like if you said “Vibrio vulnificusssssssss” with a hissing sound and a scrunched-up face. Vibrio vulnificus is best known as a human pathogen, one you might acquire from eating a raw oyster with too many of them. You might also acquire this pathogen through an open wound where it will commence to eat your flesh. And it is my baby. But, I talk about Vibrio vulnificus all the time. I’m here to talk about it and its …. siblings, if you will. The members of its genus, Vibrio.

The only photo I have of myself with my dear V. vulnificus. Actually, it’s just their DNA in a cooler. Microbiologists don’t get great “field” photos…
Vibrio make headlines because several species are pathogens, twelve out of over 110 to be exact. You may have heard of Vibrio cholerae or, as the name suggests, the pathogen responsible for Cholera (which you may remember getting in the game Oregon Trail). With rising sea surface temperatures, the frequency of some Vibrio infections is increasing and their range expanding. But Vibrio are also getting a lot of attention because they may play a much, much larger ecological role than previously believed.
Before the advent of molecular methods (studying interactions of DNA, RNA, and proteins and their biosynthesis), culture-based methods (growing bacteria on appropriate media) were king. Culture methods are still used to some extent today, but they aren’t always very accurate because of something called enrichment bias; some bacteria will grow well on media, some won’t at all. These methods indicated Vibrio abundances in the environment as high as 10% because they’re relatively easy to culture. Molecular methods remove this enrichment bias because there is not culturing, only DNA and other molecules. When molecular methods were finally introduced, abundances of Vibrio dropped to 1% of the total community. Any interest in Vibrio’s roles in the environment dropped. Scientists focused solely on the pathogenic species and their clinical impacts. How species-ist!
Now, I finally get to talk about Vibrio blooms. Vibrio have many characteristics that are (now) obvious to its ability to be a blooming bacterium, however, their blooms are so ephemeral and their consequences less obvious than phytoplankton blooms (green slime and dead fish don’t just start popping up), that they hadn’t been observed.

An Electron Micrograph (EM) of Vibrio cholerae with a single, long flagellum. The flagellum rotates and propels the cell forward. (Leodotia Pope, Department of Microbiology, University of Texas at Austin)
Vibrio have three major characteristics that make them good at blooming. First, they are able to persist in many environmental conditions. They have versatile metabolisms, having the ability to respire (like a typical consumer) in aerobic conditions and ferment in anaerobic conditions. They also can persist in oligotrophic (low nutrient) conditions and are able to go into a starvation state known as the viable but not culturable state (VBNC). Essentially, they just don’t die. Like cockroaches, they would probably survive a nuclear apocalypse. They’d probably thrive in it.
The second, which ties in very nicely with the first, is that they are able to transition out of the VBNC state rapidly. Vibrio starve in oligotrophic conditions, just waiting for an excess of nutrients, and when it arrives they binge like that one person you know who gave up on Whole 30 after a week. The third, is that they can chemotax or swim up a gradient of nutrients. This puts them at an advantage over non-motile microorganisms when those excess nutrients come into play. On paper, Vibrio have always shown signs of their ability to bloom.
It wasn’t until more recently, that we have been able to observe Vibrio blooms. Now that they’ve been seen, even though rarely, they are quite astonishing. Blooms have resulted in Vibrio abundances comprising up to 54% of the community. Remember that their typical contribution is a mere 1%! These blooms often occur simultaneously with diatom blooms and are thought to be associated either directly with iron-rich dust deposits, or indirectly via the diatoms’ extracellular products (everyone knows how much bacteria love phytoplankton waste, right?). Iron-rich dust deposits are a phenomenon seen in the Atlantic, for example, when dusts from the Sahara Desert are blown into the ocean. Vibrio blooms are thought to be occurring with these phenomena and are now being studied with much more vigor than in the past.
Vibrio spp. (and lots of them) plated on TCBS agar. Perhaps consistent and sustained monitoring of recreational and commercial water bodies will improve preparedness for Vibrio blooms and outbreaks.
With this information, scientists feel there may better opportunities for monitoring these blooms to reduce human exposure. Perhaps monitoring dust deposits via water sampling or wind patterns will one day provide enough information to warn the public of potentially high concentrations of Vibrio, especially my baby, Vibrio vulnificus, and its other pathogenic siblings, due to a bloom.
Scientists also believe that Vibrio, having this newfound blooming ability, are a big player in biogeochemical cycling. Not only do they bloom to large abundances, they are also large bacteria. At 1µm in size, individual Vibrio cells are large enough to be preferentially grazed on by zooplankton and protozoans. My poor Vibrios! But their sacrifices aren’t in vain if their energy is sent up and up the food chain. You’re welcome sharks. And humans for that matter.
The information I’ve conveyed here may not make anyone feel better about Vibrio (you’ll probably keep saying “Vibrio vulnificussssss” with a scrunched up face … or you’ll start doing it). But that’s not the point. In fact, the point for me was to show off how interesting and important (even if menacing) my laboratory babies are (we all know how parents can be, always talking about their children). But to face facts, Vibrio are not only interesting to study, they are also important to study. And they’re becoming even more important because we have only recently observed them blooming which incites so many questions about what this means for the ecosystem and, well, for us as humans. Thankfully, as is usually the case for any topic in science, the more we know about Vibrio, the more we can understand why these blooms are occurring and the better we can monitor them.
“Cholera: which you may remember getting in the game Oregon Trail.” 😂 great post Rachel! Thanks for giving pathogens personality. Do you know if Vibrio vulnificus acts as a wildlife or coral pathogen too?
LikeLike